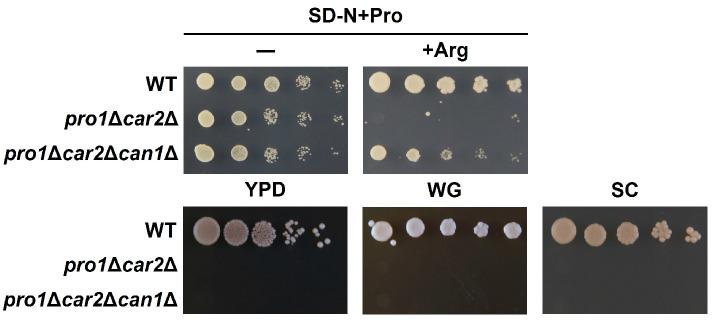
https://cdn.ncbi.nlm.nih.gov/pmc/blobs/5679/11679997/b2efb4ffb6f0/microorganisms-12-02510-g001.jpg
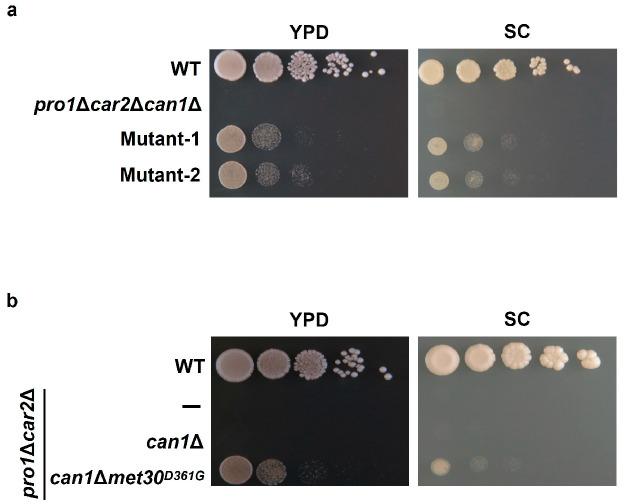
https://cdn.ncbi.nlm.nih.gov/pmc/blobs/5679/11679997/6b16ae48ea7f/microorganisms-12-02510-g002.jpg

酵母F-Box蛋白Met30在营养丰富条件下独立于转运受体Can1调节脯氨酸利用。
The Yeast F-Box Protein Met30 Regulates Proline Utilization Independently of Transceptor Can1 Under Nutrient-Rich Conditions.
作者信息
Nishimura Akira, Tanahashi Ryoya, Takagi Hiroshi
机构信息
Institute for Research Initiatives, Nara Institute of Science and Technology, 8916-5 Takayama-cho, Ikoma 630-0192, Nara, Japan.
Department of Food Science and Technology, University of California Davis, One Shields Ave., Davis, CA 95616, USA.
出版信息
Microorganisms. 2024 Dec 5;12(12):2510. doi: 10.3390/microorganisms12122510.
Proline is the most abundant amino acid in wine and beer, largely due to the limited utilization of proline by the yeast during fermentation. Previous studies have shown that the arginine transporter Can1 plays a role in regulating proline utilization by acting as a transceptor, combining the functions of both a transporter and a receptor for basic amino acids. However, the -disrupted strains have exhibited the inhibition of proline utilization under nutrient-rich conditions, indicating that additional factors beyond basic amino acids contribute to the inhibition of proline utilization. Here, we used the parent strain with the deletion to derive mutants that can utilize proline even under nutrient-rich conditions. A genomic analysis revealed a mutation in the gene, which encodes an F-box subunit of the SCF ubiquitin ligase complex, that causes reduced Met30 function. Importantly, we found that Met30 and Can1 independently regulate proline utilization. Our screening showed that the Met30-dependent inhibition of proline utilization occurs when ammonium ions, methionine or cysteine, and another amino acid (especially threonine or isoleucine) are present simultaneously. The present data offer new insights into the regulation of proline metabolism.
脯氨酸是葡萄酒和啤酒中含量最丰富的氨基酸,这主要归因于酵母在发酵过程中对脯氨酸的利用有限。先前的研究表明,精氨酸转运蛋白Can1作为一种转ceptor(兼具转运蛋白和碱性氨基酸受体的功能),在调节脯氨酸利用方面发挥作用。然而,基因敲除菌株在营养丰富的条件下表现出脯氨酸利用受到抑制,这表明除碱性氨基酸外,还有其他因素导致脯氨酸利用受到抑制。在此,我们使用基因缺失的亲本菌株来获得即使在营养丰富条件下也能利用脯氨酸的突变体。基因组分析揭示了基因中的一个突变,该基因编码SCF泛素连接酶复合体的一个F-box亚基,导致Met30功能降低。重要的是,我们发现Met30和Can1独立调节脯氨酸利用。我们的筛选表明,当铵离子、甲硫氨酸或半胱氨酸以及另一种氨基酸(尤其是苏氨酸或异亮氨酸)同时存在时,会发生Met30依赖的脯氨酸利用抑制。目前的数据为脯氨酸代谢的调节提供了新的见解。